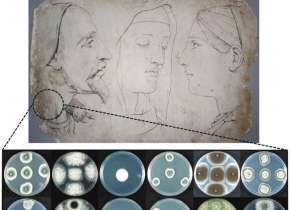

哥斯达黎加的科学家发现了一些新的真菌品种,这些真菌的藏身之处有些特别——它们生活在19世纪法国艺术家伯纳德·罗曼·朱利安(Bernard Romain Julien)的石版画(lithograph)里。这种印刷艺术品是哥斯达黎加大学最古老的艺术藏品之一,用作学习绘画技法的工具。然而微生物却会加速这些印刷艺术品的腐蚀。
为了保护石版画,哥斯达黎加大学化学系和艺术研究学院的研究员杰拉尔丁·康乔-巴尔沃扎(Geraldine Conejo-Barboza)和同事正在研制一种喷雾,这种喷雾既可以清除真菌或抑制真菌生长,又能阻止会让艺术品变质的自然酸化过程。“有研究发现,羟基磷灰石分子可以降低纸张的酸度。我们的想法是,利用羟基磷灰石合成出一种新的、兼有清除真菌功能的分子,”康乔-巴尔沃扎说。她计划在羟基磷灰石的表面添加氧化锌和锌离子,以达到抗菌的效果。
然而,就像一个人在服药之前必须先搞清患的是什么病。为了找到正在破坏艺术品的“真凶”,哥斯达黎加生物技术创新中心的分子生物学家马克斯·查瓦里亚(Max Chavarría)从1000多件石版画藏品中选出20件进行研究,并从中提取出了21种真菌样本,其中有两种真菌是首次被发现。查瓦里亚说:“在如此有限的环境中,就能发现两种新的生物,真的令人吃惊。”研究人员将新发现的两种真菌命名为Periconia epilithographicola和Coniochaeta cipronana,相关结果已经发表在今年5月的《科学报告》杂志上。
康乔-巴尔沃扎已经合成了一些抗真菌产品,并计划在实验室中进行测试。过去5年中,哥斯达黎加大学艺术研究学院的副院长所罗门·查维斯(Salomón Chaves)一直致力于石版画的修复,他评价说,“这种喷雾式的新产品很有优势”。因为,目前防止纸张酸化的方法是先将其浸泡在碱性物质中,然后再小心翼翼地取出弄干,一旦操作不当纸张就会皱缩。研究人员希望,新的化学品能有效对抗微生物腐蚀和自然酸化过程,对其他地方的藏品也能起到保护作用。其实真菌并非都是有害的。例如,真菌具有降解纤维素(纤维素是构成植物细胞壁的一种坚硬物质)的能力,能够降解菠萝、咖啡、甘蔗等农作物的废弃物。
撰文:Debbie Ponchner
翻译:杨风丽